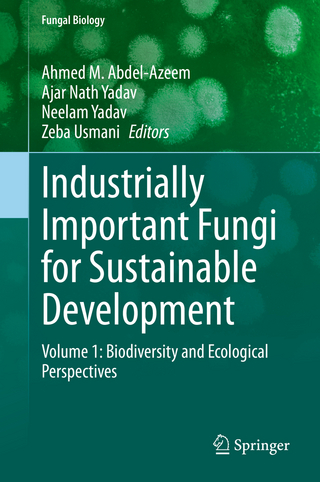
Industrially Important Fungi for Sustainable Development

The Ultimate Guide to Coloring Wood with Fungi
Buch | Softcover
2021
|
Schiffer Publishing Ltd
ISBN: 9780764360893
CHF 41,90 (inkl. MwSt)
- Versand in
10-20 Tagen